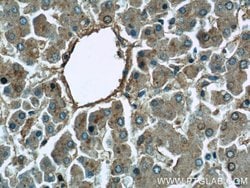

missing translation for 'onlineSavingsMsg'
Learn More
Learn More
MAPKSP1 Rabbit anti-Human, Mouse, Rat, Polyclonal, Proteintech
Rabbit Polyclonal Antibody
145.00 - 410.00
Specificatie
| Antigeen | MAPKSP1 |
|---|---|
| Concentratie | 0.21 mg/mL |
| Toepassingen | Immunohistochemistry (Paraffin), Western Blot |
| Classificatie | Polyclonal |
| Conjugaat | Unconjugated |
| Produktcode | Merk | Aantal | Prijs | Hoeveelheid en beschikbaarheid | |||||
|---|---|---|---|---|---|---|---|---|---|
| Produktcode | Merk | Aantal | Prijs | Hoeveelheid en beschikbaarheid | |||||
|
16859333
|
Proteintech
11937-1-AP-20UL |
20 μL |
145.00
|
Please sign in to purchase this item. Need a web account? Register with us today! | |||||
|
16849333
|
Proteintech
11937-1-AP-150UL |
150 μL |
410.00
|
Please sign in to purchase this item. Need a web account? Register with us today! | |||||
Beschrijving
This gene encodes a scaffold protein that functions in the extracellular signal-regulated kinase (ERK) cascade. The protein is localized to late endosomes by the mitogen-activated protein-binding protein-interacting protein, and binds specifically to MAP kinase kinase MAP2K1/MEK1, MAP kinase MAPK3/ERK1, and MAP kinase MAPK1/ERK2. Studies of the orthologous gene in mouse indicate that it regulates late endosomal traffic and cell proliferation. Alternatively spliced transcript variants encoding multiple isoforms have been observed for this gene. A pseudogene of this gene is located on the long arm of chromosome 13.Specificatie
| MAPKSP1 | |
| Immunohistochemistry (Paraffin), Western Blot | |
| Unconjugated | |
| Rabbit | |
| Mouse, Human, Rat | |
| O88653, Q5U204, Q9UHA4 | |
| 362045, 56692, 8649 | |
| MAPKSP1 Fusion Protein Ag2534 | |
| Primary | |
| -20°C | |
| LAMTOR3 |
| 0.21 mg/mL | |
| Polyclonal | |
| Liquid | |
| RUO | |
| PBS with 50% glycerol and 0.1% sodium azide; pH 7.3 | |
| LAMTOR3, MAP2K1IP1, MAPBP, MAPK scaffold protein 1, MAPKSP1, MEK binding partner 1, MP1 | |
| Lamtor3 | |
| IgG | |
| Antigen Affinity Chromatography | |
| Antibody |
Spot an opportunity for improvement?Share a Content Correction
Product Content Correction
Your input is important to us. Please complete this form to provide feedback related to the content on this product.
Product Title